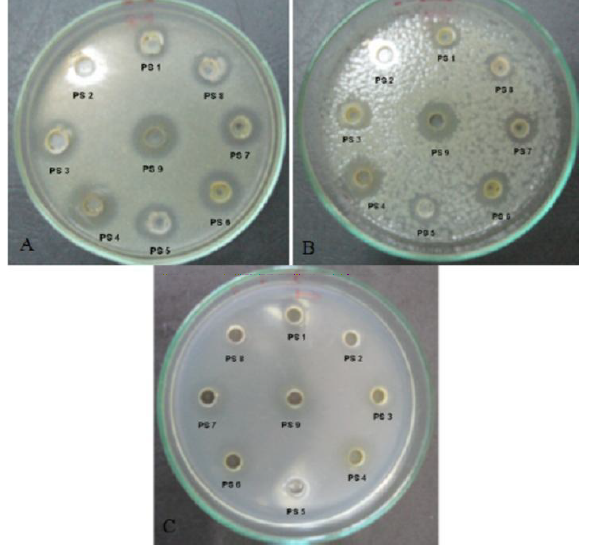

1P. K. Roy Memorial College Dhanbad, Jharkhand, India, 2Nitza Bioventure Hyderabad, Telangana, India
Email: swetavishwakarma3011@gmail.com
Received: 16 Nov 2019, Revised and Accepted: 22 Jan 2020
ABSTRACT
Objective: The objective of this study was to evaluate the antibacterial activity of some plant extracts they are-Curcuma longa, Cinnamomum tamala, Ocimum tenuiflorum, Azadirachta indica, Datura stramonium, Zingiber officinale, Punica granatum and Cinnamomum cassia against Staphylococcus aureus and E. coli.
Methods: The evaluation of antibacterial activity for different extracts of each plant was carried out by using the disc diffusion method and by pouring technique to determine the minimum inhibitory concentration (MIC).
Results: In the disc diffusion method the plant extracts showed zone of inhibition ranging 02.0 to 16.0 mm against bacteria and In pouring technique plant extracts showed positive control against pure culture of a bacterium and their efficiency in terms of MICs where ranged from 0.2 gm/ml to 0.8 gm/ml. The extracts of Curcuma longa and Cinnamomum tamala shown high efficiency then other plant extracts in terms of zone of inhibition and also in pouring technique less amount of extracts was inhibited the growth of bacteria.
Conclusion: This study indicates that extracts of these plants have antibacterial activity against bacteria. This report supports their use in the treatment of infections caused by bacteria.
Keywords: Minimum Inhibitory Concentration, Antibacterial, Cinnamomum tamala, Staphylococcus aureus
© 2020 The Authors. Published by Innovare Academic Sciences Pvt Ltd. This is an open-access article under the CC BY license (http://creativecommons.org/licenses/by/4.0/)
DOI: http://dx.doi.org/10.22159/ijcpr.2020v12i2.37484. Journal homepage: https://innovareacademics.in/journals/index.php/ijcpr
INTRODUCTION
The uses of antibiotics are widespread in clinical medicine, agriculture, and veterinary promote the development of antibiotic resistances among infectious microbial strains and eventually reflects a very serious problem in the treatment of pathogenic microbes [1], this has led to the search of new antimicrobial agents mainly among plant extracts with the goal to discover new chemical structures which overcome the above disadvantages [2]. Natural products are typically secondary metabolites, produced by plants and microorganisms in response to external stimuli such as nutritional changes. They are widely used in the pharmaceutical industry for their remarkable structural diversity and range of pharmacological activities [3]. Plants have been used for centuries to treat infectious diseases and are considered as an important source of new antimicrobial agents [4]. Several works have been done to examine the antimicrobial effects of herbal plants extracts, including roots, stem, leaves or flowers [5].
Many countries in India and other parts of the world have continued to encourage screening programs of plants used in traditional medicine in order to authenticate their antimicrobial activities and possible inclusion in primary health care. Like the other countries of the Maghreb and Africa, the empirical use of medicinal plants continues to retain great popularity in Algeria. In some rural areas, resorting to natural remedies with “miraculous” plants is preferred to modern medicine.
Ocimum tenuiflorum
O. tenuiflorum popularly known as holy basil, is arguably one of the most important plants in India. It is of both religious and medicinal value and found to grow well in moist soil.
Pharmacological studies have shown that the plant possesses antifertility, anticancer, antidiabetic, antifungal, antimicrobial, hepatoprotective, cardioprotective, antiemetic, antispasmodic, analgesic, adaptogenic, diaphoretic, antimalarial, anti-inflammatory and antipyretic properties [6] (fig. 1).
Azadirachta indica
Azadirachta indica, commonly known as neem, has attracted worldwide prominence in recent years, owing to its wide range of medicinal properties. Neem has been extensively used in Ayurveda, Unani and Homoeopathic medicine and has become a cynosure of modern medicine. More than 140 compounds have been isolated from different parts of neem. All parts of the neem tree leaves, flowers, seeds, fruits, roots and bark have been used traditionally for the treatment of inflammation, infections, fever, skin diseases and dental disorders. The medicinal utilities have been described especially for neem leaf. Neem leaf and its constituents have been demonstrated to exhibit immunomodulatory, anti-inflammatory, antihyperglycemic, antiulcer, antimalarial, antifungal, antibacterial, antiviral, antioxidant, antimutagenic and anticarcinogenic properties [7] (fig. 2).
Datura stramonium
Datura is an herbaceous perennial plant, which is grown in the temperate and tropical regions of the globe. All the species of Datura are poisonous in nature. Some are aphrodisiac too. The seeds and flowers are more poisonous in nature. However, in Ayurveda, it is used as medicine and ritual as well as prayers has also place this. Even being a poisonous plant, datura has been using since ancient times by Ayurveda physicians, spiritual purposes, holy men and its use in modern medicine drugs [8].
The ointment is used to apply on the soles of the feet, vagina and armpits. Datura has been used in Ayurveda for asthma symptoms where jimson weed’s leaves are smoked in cigarette or pipe. The Zuni once used it as analgesic for bone setting while the Chinese were used it as anesthesia during surgery [9] (fig. 3)
Zingiber officinale
Ginger is a flowering plant that originated from China. It belongs to the Zingiberaceae family and is closely related to turmeric, cardamom and galangal. The rhizome (underground part of the stem) is the part commonly used as a spice. It is often called ginger root, or simply ginger. It has been used to help digestion, reduce nausea and help fight the flu and common cold, to name a few. Gingerol is the main bioactive compound in ginger, responsible for much of its medicinal properties. It has powerful anti-inflammatory and antioxidant effects [10] (fig. 4).
Cinnamomum cassia
Cassia is an important medicinal and traditional plant with diverse chemical, pharmacognosy, and pharmacological spectrum. This plant is used by traditional medical practitioners for the treatment of various diseases. It is known as a rich source of tannins, flavonoids and glycosides present in Cassia might be medicinally important and/or nutritionally valuable. The plant is rich in carbohydrates, Linoleic, Oleic, and Stearic [11]. (fig. 5)
Cinnamomum tamala
Cinnamomum tamala is an evergreen tree growing 10-20 metres tall. The bole can be 20 cm in diameter. It is a popular spice in northern India and Pakistan, where the plant is harvested from the wild and also often cultivated. The bark and leaves, which are sources of essential oils, are the parts mainly used and they also have medicinal properties. The dried bark is used to treat stomach-ache. The leaves are used in the treatment of colic and diarrhoea. Leaf extracts produce a hypoglycaemic effect in experimental rats. The hydro distilled essential oils, when screened for their antifungal activity against Trichophyton mentagrophytes and Microsporum audounil (which cause ringworm diseases in animals and humans), exhibited fungicidal or fungistatic toxicity and were more effective than the synthetic antifungal agents, clotrimazole, griseofulvin or nystatin [12]. (fig. 6).
Curcuma longa
Curcuma longa, a rhizomatous herbaceous perennial plant belonging to the ginger family Zingiberaceae, which is native to tropical South Asia. As many as 133 species of Curcuma have been identified worldwide. Most of them have common local names and are used for various medicinal formulations [13].
The present study was aimed to determine the potential antibacterial activities of extracts from eight selected medicinal plants organs belonging to different families on human pathogenic bacteria, in order to valorize them in the light of previous works for further application in food and pharmaceutical industries as natural valuable products (fig. 7)

Fig. 1: Ocimum tenuiflorum Fig. 2: Azadirachta indica Fig. 3: Datura stramonium

Fig. 4: Zingiber officinale Fig. 5: Cinnamomum cassia Fig. 6: Cinnamomum tamala

Fig. 7: Curcuma longa
MATERIALS AND METHODS
Collection of plant materials
The fresh and healthy Ocimum tenuiflorum (leaves), Azadirachta indica (leaves), Datura stramonium (leaves), Zingiber officinale (stem), Cinnamomum cassia (bark of stem), Cinnamomum tamala (leaves) and Curcuma longa (rizhomes) were collected on August, 2019 from various areas of Dhanbad District, Jharkhand, India.
Preparation of plant extracts
20 g powder of each tested plant material was soaked in 180 ml of distilled water in a round bottom flask and heated for 30 min at 90 °C, before the overnight incubation at 37 °C, and 150 rpm in a shaking incubator [14]. Similarly, 10 g powder of each tested plant material was mixed with water (9:1) separately in round bottom flasks and incubated at 37 °C and 150 rpm for overnight. Liquid extracts obtained were separated from the solid residue by filtration using Whatman No. 1 filter, and then concentrated.
Microbial culture
The antimicrobial properties of plant extracts were tested against Staphylococcus aureus and E. coli. Then colonies were pre-cultured in Mueller Hinton broth (MHB) overnight in a rotary shaker at 37 °C. Afterward, each strain was adjusted at a concentration of 108 cells/ml using 0.5 McFarland standard [15].
Minimum inhibitory concentration (MIC)
For agar dilution method Mueller Hinton agar (MHA, Hi-Media) plates having 5.12, 2.56, 1.28, 0.64, 0.32, 0.16, 0.08, 0.04 and 0.02 μgm/ ml of MHA were used [16] and test strains were spot inoculated from overnight broth culture with a sterile loop and incubated for 24 h at 37oC. The growth of bacteria was determined by the formation of bacterial colony on the site of inoculation and on the extract’s dilution plate at which the inoculated bacteria did not grew was taken as MIC of extracts for the test strain.
For broth dilution method, extracts were first diluted (51.2 μgm/ml) in water and then 200 μgm of it was dispensed into the first tube having 1.9 ml of Mueller Hinton broth (MHB, Hi-Media) to have final dilution of 5.12 μgm of extracts/ml. From the first tube one ml was transferred to the second tube having one ml of sterile MHB, and such two-fold serial dilutions were made up to 9th tube to have 5.12, 2.56, 1.28, 0.64, 0.32, 0.16, 0.08, 0.04 and 0.02 μl extracts/ml of MHB in first to 9th tube, respectively. To each tube 10 μl of overnight grown test culture was added and incubated at 37oC for 24 hr. and observed for growth of bacteria. The highest dilution where growth was not observed (no turbidity) was recorded as MIC of extracts for the test strain.
For agar well method eight two-fold serial dilutions of extracts (102.4 to 0. 8 μl/ml) were made in the water while the 9th tube contained only water. Six mm diameter eight wells were cut in MHA plate in a circle (1 cm inside to the periphery of the plate) and 9th well was cut in the center of the plates pretested for sterility through 36 h incubation at 37oC. Bases of wells were sealed using 10 l of sterile molten MHA. Thereafter, MHA plates were inoculated using swabs dipped in overnight test culture of bacteria grown in MHB. After inoculation plates were allowed to dry for 15 min at ambient temperature in laminar flow before dispensing of diluted extracts from well number one to nine. The well with the highest dilution showing clear zone of growth inhibition was considered as the MIC well and MIC was calculated by dividing the extract concentration dispensed in the MIC well by 20, viz., if the MIC well was the 3rd well (fig. 6.1) then MIC was equal to 1.28 μl/ml. All tests were conducted in triplicate.
Determination of zone of inhibition
A qualitative method was used to measure antimicrobial resistance activity of plant extracts. Single strain is spread over an agar plate using a sterile swab, then incubated in the presence of the plant extract.
If strain is susceptible to the antibacterial agent, then a zone of inhibition appears on agar plate after it is incubated for 18-24 h. The diameter of the zone of inhibition is usually related to level of antimicrobial activity present in the plant extract. A larger zone of inhibition usually means that the antimicrobial is more potent [17].
RESULTS AND DISCUSSION
The profile of the medicinal plants used in this study and the results of antibacterial activity of both water crude extracts showed good activity on the strains of gram-positive and gram-negative bacteria, tested at different concentrations, by diameter of zone of inhibitions (table 1) (fig. 8) and minimum inhibitory concentration (MIC) (table 2).
Table 1: Antibacterial activity of plant extracts.
| Plants name | E. coli (mm) | Staphylococcus aureus (mm) |
| Ocimum tenuiflorum | 0.23 | 0.36 |
| Azadirachta indica | 0.20 | 0.48 |
| Datura stramonium | 0.23 | 0.25 |
| Zingiber officinale | 0.42 | 0.45 |
| Cinnamomum cassia | 0.60 | 0.50 |
| Cinnamomum tamala | 10.5 | 0.86 |
| Curcuma longa | 12.02 | 16.0 |
Fig. 8: Zone of inhibition (Antibacterial Activity)
Table 2: Minimum inhibitory concentration (MIC) of plant extracts
| Plants name | E. coli (Gm/ml) | Staphylococcus aureus (Gm/ml) |
| Ocimum tenuiflorum | 0.8 | 0.8 |
| Azadirachta indica | 0.8 | 0.8 |
| Datura stramonium | 0.6 | 0.6 |
| Zingiber officinale | 0.6 | 0.7 |
| Cinnamomum cassia | 0.2 | 0.2 |
| Cinnamomum tamala | 0.2 | 0.2 |
| Curcuma longa | 0.2 | 0.2 |
CONCLUSION
Currently, microbial infections have become an important clinical threat, with significant associated morbidity and mortality which is mainly due to the development of microbial resistance to the existing antimicrobial agents. Therefore, methods for antimicrobial susceptibility testing and discovering novel antimicrobial agents have been extensively used and continue to be developed. Some techniques were subjected to standardization by the CLSI and EUCAST marking the major remarkable steps on this field. However, when testing natural products, some modifications of the standardized protocols are often requested. Thus, it is imperative to be careful not to change the basics of microbiology by diluting the culture media and using a highly concentrated inoculum. Moreover, if we consider the use of solvents that may affect the growth of the microorganism tested, we can say that making minor methodological adaptations to standardized protocols can be a solution to ensure the accurate experimental approach and allow other researchers to compare results.
Nil
All the author have contributed equally.
Declared none
REFERENCES
Al-Hashimi AG, Antioxidant and antibacterial activities of hibiscus sabdariffa L. extracts. Afr J Food Sci 2012;6:506-11.
Alzoreky NS, Nakahara K. Antibacterial activity of extracts from some edible plants commonly consumed in Asia. Int J Food Microbiol 2003;80:223-30.
Aono R, Ito M, Horikoshi K. Measurement of cytoplasmic pH of the alkaliphile Bacillus lentus C-125 with a fluorescent pH probe. Microbiology 1997;143:2531-6.
Azziz Baumgartner E, Lindblade K, Gieseker K, Rogers HS, Kieszak S, Njapau H, et al. Case-control study of an acute aflatoxicosis outbreak, Kenya, Environ Health Perspect 2005;113:1779–83.
Bhalodia NR, Shukla VJ. Antibacterial and antifungal activities from leaf extracts of Cassia fistula l.: an ethnomedicinal plant. J Adv Pharm Technol Res 2011;2:104–9.
Caleja C, Barros L, Antonio AL, Carocho M, Oliveira MB, Ferreira IC. Fortification of yogurts with different antioxidant preservatives: a comparative study between natural and synthetic additives. Food Chem 2016;210:262–8.
Clarke D, Tyuftin AA, Cruz Romero MC, Bolton D, Fanning S, Pankaj SK. Surface attachment of active antimicrobial coatings onto conventional plastic-based laminates and performance assessment of these materials on the storage life of vacuum-packaged beef sub-primals. Food Microbiol 2017;62:196-201.
Clementi EA, Marks LR, Roche Hakansson H, Hakansson AP. Monitoring changes in membrane polarity, membrane integrity, and intracellular ion concentrations in Streptococcus pneumoniae using fluorescent dyes. J Visualized Exp 2014;84:1-8.
Daoud A, Malika D, Bakari S, Hfaiedh N, Mnafgui K, Kadri A. Assessment of polyphenol composition, antioxidant and antimicrobial properties of various extracts of date palm pollen. Arabian J Chem 2019;12:3075-86.
Dhanani T, Shah S, Gajbhiye NA, Kumar S. Effect of extraction methods on yield, phytochemical constituents and antioxidant activity of Withania somnifera. Arabian J Chem 2017;10:S1193-S1199.
Fernandez Lopez J, Zhi N, Aleson Carbonell L, Perez Alvarez JA, Kuri V. Antioxidant and antibacterial activities of natural extracts: application in beef meatballs. Arabian J Chem 2005;59:3431-55.
Mau JL, Chen CP, Hsieh PC. Antimicrobial effect of extracts from Chinese chive, cinnamon, and corni fructus. J Agric Food Chem 2001;49:183–8.
Molina Gutierrez A, Stippl V, Delgado A, Ganzle MG, Vogel RF. In situ determination of the intracellular pH of Lactococcus lactis and Lactobacillus plantarum during pressure treatment. Appl Environ Microbiol 2002;68:4399-406.
Oonmetta Aree J, Suzuki T, Gasaluck P, Eumkeb G. Antimicrobial properties and action of galangal (Alpinia galanga linn.) on Staphylococcus aureus. LWT Food Sci Technol 2006;39:1214-20.
Sanchez E, Garcia S, Heredia N. Extracts of edible and medicinal plants damage membranes of Vibrio cholera. Appl Environ Microbiol 2010;76:6888-94.
Gurnani N, Gupta M, Shrivastava R, Mehta D, Mehta B. Effect of extraction methods on yield, phytochemical constituents, antibacterial and antifungal activity of Capsicum frutescens L. Indian J Nat Prod Resour 2016;7:32-9.
Mostafa AA, Al-Askar AA, Almaary KS, Dawoud TM, Sholkamy EN, Bakri MM. Antimicrobial activity of some plant extracts against bacterial strains causing food poisoning diseases. Saudi J Biol Sci 2018;25:361-6.